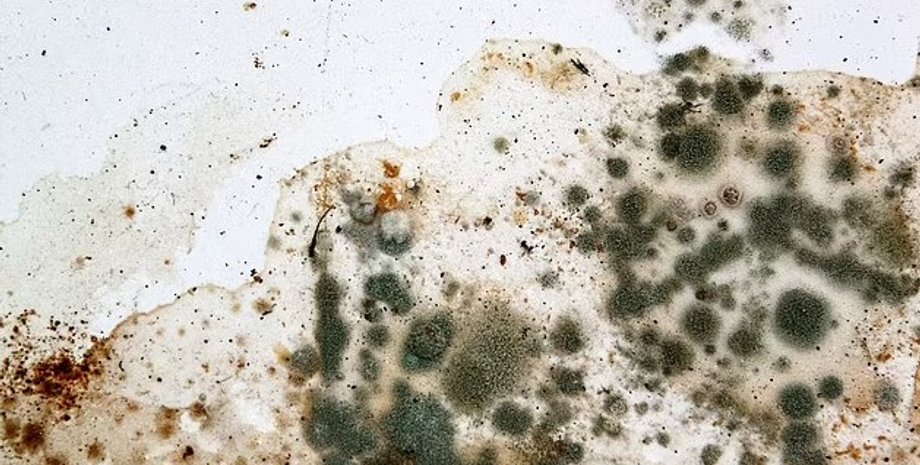
плесень, черная плесень

Всех цветов радуги. Создан гайд по плесени: какую опасность таит грибок в зависимости от цвета
Все, что нужно знать о грибковых образованиях — от бархатно-голубой плесени в вазе с фруктами и до черного пятна в душе.
Плесень — то, что мы все боимся увидеть у себя в доме. Эти грибковые наросты процветают во влажных условиях и могут возникать в различных местах, будь то стена, картонная коробка, продукты или даже пыль, пишет Daily Mail.
Хотя мы не всегда способны заметить плесень сразу, споры могут проявляться в разных цветах — от желтого и черного и до фиолетового. Эксперт из Университета Флиндерса Майкл Тейлор рассказал, каких видов бывает плесень и чем она опасна для человека.
У Фокус. Технологии появился свой Telegram-канал. Подписывайтесь, чтобы не пропускать самые свежие и захватывающие новости из мира науки!
Черная плесень
Токсичная черная плесень, также известная как "Стахиботрис", растет и размножается на поверхностях, которые долгое время были слишком влажными, например, стенах дома. Ученый отмечает, что воздействие этого вида может сделать человека более восприимчивым к респираторным инфекциям, астме, а порой даже может привести к летальному исходу.
Статистика свидетельствует о том, что только в Великобритании около 40% всех домов, сдаваемых в аренду, подвержены плесени. В то же время Тейлор отмечает, что слизистая черная плесень, обнаруженная в душе, может принадлежать к совершенно иному типу.
Ауреобазидиум — дрожжеподобный грибок, который также моет вызвать аллергическую реакцию у человека, но едва ли угрожает нашей жизни. Ученый отмечает, что в этом случае может помочь отбеливание — грибок будет уничтожен, однако темная пигментация, вероятно, останется в душе. Впрочем, не навредит здоровью.
Зеленая плесень
Многие из нас сталкивались с этим видом плесени, когда забывали о чем-то в холодильнике, а со временем обнаруживали, что продукт покрыт зеленоватым пухом. Несмотря на то, что у нас может возникнуть соблазн попросту срезать зеленоватые поврежденные кусочки, Тайлер предупреждает, что это вовсе не сработает — так просто от плесени не избавиться.
Исследователь отмечает, что часто люди попросту отрезают плохой кусок, думая, что таким образом могут спасти часть продукта, однако так это не работает. Дело в том, что корни грибов (мицелий) распространяются через пищу, переваривая и собирая значительное количество питательных веществ, чтобы выпустить ряд крохотных плодовых тел, которые и производят цветные споры, видимые на поверхности.
В группу мицелия входит грибок Aspergillus, который особенно хорошо процветает в жару и даже любит кислоту. Его споры могут месяцами оставаться в воздухе и вызвать инфекции у людей с ослабленным иммунитетом.
По словам консультанта по пищевой гигиене в Лондоне Сильвии Андерсон, лишь некоторые продукты в действительности остаются безопасными для употребления, если срезать с них все поврежденные кусочки. Среди них фрукты, овощи, а также твердые сыры, салями и мармелад.
Триходерма ("волосатая кожа") — также относится к зеленой плесени, которая возникает в домах и может быть опасной для человека. Как правило, она произрастает на влажных коврах и картоне. Исследователи предупреждают, что от такой плесени может быть сложно избавиться, однако некоторые дезинфицирующие средства все же могут полностью истребить споры.
Розовая и фиолетовая плесень
Розовый осадок может время от времени появляться вокруг кранов или в углах душа. По словам Тайлера, эта плесень известна как Serratia — тип грибка, способный выживать в жидком мыле и средствах для мытья рук. В наиболее худших случаях споры этой плесени могут вызывать многочисленные инфекции, в том числе сепсис, который проявляется лихорадкой и ознобом.
Впрочем, исследователи отмечают, что частая дезинфекция отбеливателем и другими моющими средствами может помочь удерживать плесень под контролем.
Гораздо реже в домах также встречается пурпурная плесень (фузариоз). Как правило, она возникает на цементе, который долгое время оставался влажным. По словам Тайлера, фузариоз образует больше, липкие, лунообразные споры, которые эволюционировали, чтобы распространяться с брызгами дождя и цепляться за растения.
Желтая и оранжевая плесень
Stemphylium и Epicoccum — желтые и оранжевые плесневые грибы, которые также встречаются в доме. По словам Тейлора, эти виды плесени, как правило, цепляются за натуральные волокна, такие как конопля и джут, который часто используется для изготовления плетеной мебели.
Еще одним материалом, на котором такая плесень будет процветать, если получат достаточное количество ультрафиолета, является гессен. По словам исследователя, люди часто ошибочно думают о грибах, как об организмах, которые процветают в темноте, но это не совсем так. На самом же деле, некоторым из них в действительности необходимо воздействие света, чтобы завершить свой жизненный цикл.
По словам Тейлора, многие патогены растений используют воздействие ультрафиолета в качестве триггера для производства своих спор, а затем защищают свою ДНК, скрывая ее за оболочками, содержащими меланин.
Мы также можем обнаружить желтые споры в саду, которые еще называют "ржавчиной дерновой травы". Эта плесень, как правило, появляется на листьях растений. Однако от нее можно легко избавиться, пересадив то, что у вас выросло.
Синяя плесень
При упоминании о голубой плесени, вы можете вспомнить такие сыры, как стилтон, горгонзола и дольчелатте. По словам Тейлора, за это мы должны быть благодарны грибам Penicillium, которые также являются родом, ответственным за антибиотик пенициллин.
Эти грибы являются съедобными, так как кислотность, соленость и температура сыра предотвращают рост токсинов. Но с другой стороны, эти же грибы также вызывают гниение продуктов в наших шкафах и даже почве.
Белая плесень
На самом деле существует множество видов белой плесени, однако наиболее распространенным является Cladosporium, возникающий в домашних условиях. Этот вид может передаваться воздушно-капельным путем и обычно встречается во влажных помещениях, например, подвалах, ванных комнатах и на чердаках.
Исследователи также отмечают, что эта плесень может появляться на коврах, в вентиляционных отверстиях, а порой даже на бумаге. Большинство форм этой плесени не опасны для человека, однако они все же могут усугубить астму и аллергию.
По словам Тейлора, в саду мы также можем встретить другой тип белой плесени (Isaria farinosa). Визуально этот вид похож на кораллы и является паразитом мотыльков и цикад, которые часто используются для борьбы с вредителями.
Ранее Фокус писал о том, что ученые предупреждают, что мы неправильно пользуемся пылесосом.
Этот материал носит исключительно информационный характер и не содержит советов, которые могут повлиять на ваше здоровье. Если вы испытываете проблемы, обратитесь к специалисту.





